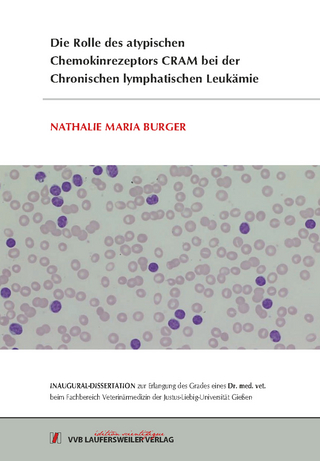
Die Rolle des atypischen Chemokinrezeptors CRAM bei der Chronischen lymphatischen Leukämie

Buch
2013
|
Mensch & Buch
ISBN: 9783863874049
CHF 34,85 (inkl. MwSt)
- Titel ist leider vergriffen;
keine Neuauflage